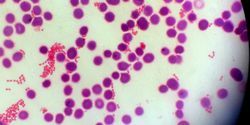
A Closer Look at Multiplex Panels for Respiratory, Gastrointestinal, and Blood Pathogens

Influenza Diagnostic Methods: RT-PCR vs. RIDTs
RT-PCR is considered the gold standard, but certain situations may call for the use of RIDTs
The 2017-2018 flu season in the U.S. was the worst recorded since 1976. There were an estimated 80,000 deaths and a record 900,000 hospitalizations for influenza and its complications. Rapid and accurate diagnosis of influenza can save lives by facilitating early treatment, save money by preventing inappropriate treatment, and prevent epidemics by minimizing viral transmission.
For accurate diagnosis, reverse transcription PCR (RT-PCR) is considered the gold standard. Rapid influenza diagnostic tests (RIDTs), although fast and convenient, often produce false-negative results. In fact, the WHO recommends that “in general, the use of RIDTs in hospitalized patients should not be encouraged where RT-PCR or immunofluorescence assays for influenza are available.”
And yet, both the CDC and the WHO include RIDTs in their repertoire of recommended diagnostic tools. This article explores the two very different tests and discusses when and why clinicians choose one or the other.
Ease of use and portability
RIDTs are simple-to-use dipsticks, cards, or cassettes that do not require laboratory conditions or extensive training—a huge benefit to isolated clinics with minimal staff and laboratory equipment. Their size makes them easily transportable and, when kept between 4?C and 30?C, RIDTs are viable for around 18 months.
RT-PCR, in contrast, must be performed by highly-trained staff using bulky, expensive equipment in dedicated laboratories. In the U.S., the tests must be performed at accredited clinical laboratories and in developing countries, clinics may need to send samples many miles to diagnostic centers.
Speed of diagnosis
The greatest benefit of the RIDTs is the short test time: less than 15 minutes, compared to one to eight hours for RT-PCR. RIDTs are point-of-care (POC) tests, so samples do not have to be sent to centralized laboratories; therefore, clinicians can start anti-viral treatment much sooner, which is vital for high-risk patients. The CDC recommends that clinics should not wait for laboratory confirmation of influenza before beginning antiviral treatment.
Specificity and sensitivity
RT-PCR is considered the most accurate method of diagnosis, with 90 to 100 percent sensitivity (the rate of true positive results) and specificity (the rate of true negative results) depending on the strain, patient age, and day of testing. The PCR method may have slightly reduced sensitivity after day three of infection in adults, but it performs better than other tests at this time. By using primers specific to RNA sequences, RT-PCR can confirm influenza as well as distinguish between strains and subtypes. Further analysis can identify a strain’s susceptibility to anti-viral agents, a useful resource during an epidemic. However, laboratorians must update primers regularly to keep up with antigenic shift and maintain test reliability.
RIDTs have a specificity of 90 to 95 percent, resulting in few false-positives. Their reported sensitivity varies from as low as 4.4 percent to 100 percent, and most often between 40 and 70 percent, so false-negatives are common, especially during peak influenza seasons. RIDTs display much higher sensitivity if used within the first three days of infection, or within seven days for children. Most kits can distinguish between influenza A and B but not subtypes within A or B: In 2009, RIDTs could not distinguish pandemic H1N1 influenza A infection from the seasonal influenza A viruses.
Cost
RIDTs cost around $20 each, while RT-PCR tests are higher at $90, and real-time RT-PCR is significantly more. Transportation costs for isolated clinics increases the price of RT-PCR further. For many clinics in the developing world, RIDTs are the only affordable tests available.
In addition, a study of health insurance claims in the U.S. revealed that use of antiviral drugs dropped by almost 50 percent when RIDTs were used to diagnose influenza compared to no clinical test. The average cost of treatment when RIDTs were used was $62.46 compared to $192.83 after medical diagnosis without RIDTs. In 2003, the total medical cost of influenza in the U.S. was an estimated $10.4 billion; clearly, further use of RIDTs could make a substantial impact on this expenditure.
Controversies and limitations
The high variance in RIDT sensitivity is a result of a myriad factors such as influenza type, viral titer, patient age-group, sample source, and experience and ability of the tester. Studies into RIDTs often vary in these factors, as well as in the RIDT kit used. It is very difficult, therefore, to assess the sensitivity accurately until more standardized studies are deployed.
Several new RIDTs have been developed with improved sensitivity. The BD Veritor system can detect much lower levels of influenza virus by employing an optical reader, with a sensitivity of 70 to 90 percent. The reader costs $300 and each cartridge is $16, adding a small amount to the cost of an individual test.
On the other hand, faster and more portable POC tests based on nucleic acid amplification technologies may someday provide clinic-based molecular testing comparable to RT-PCR. At around $50 per test, these POC tests are more expensive than RIDTs and require accurate and careful sample collection and expensive reading equipment. Sensitivities for these rapid molecular tests are more variable than traditional RT-PCR tests, so are not yet considered an adequate replacement.
Choice of test
Ultimately, the choice between the RIDT and RT-PCR methods is based on several factors. In an understaffed, ill-equipped clinic, or in the peak of an epidemic, RIDTs may be employed to confirm the influenza type for some of the patients presenting with influenza-like symptoms, but with the majority receiving treatment without confirmed testing. In such a situation, samples are collected for laboratory testing, using the RT-PCR gold standard to confirm infection type and subtype, for future reference and for use in epidemic recording and control.
In less manic times, RIDTs are a useful, inexpensive and rapid method of confirming influenza, and in some clinics they may be the only diagnostic tool available. When a negative RIDT result is obtained, clinicians must take other factors—such as exposure, risk of infection, severity of illness, and differential diagnosis—into account when deciding whether treatment or further testing is required.
Researchers have yet to confirm the benefits that newer tests can provide. If they are able to overcome the limitations of the current methods successfully, they will inevitably become the next must-have influenza diagnostic tools.